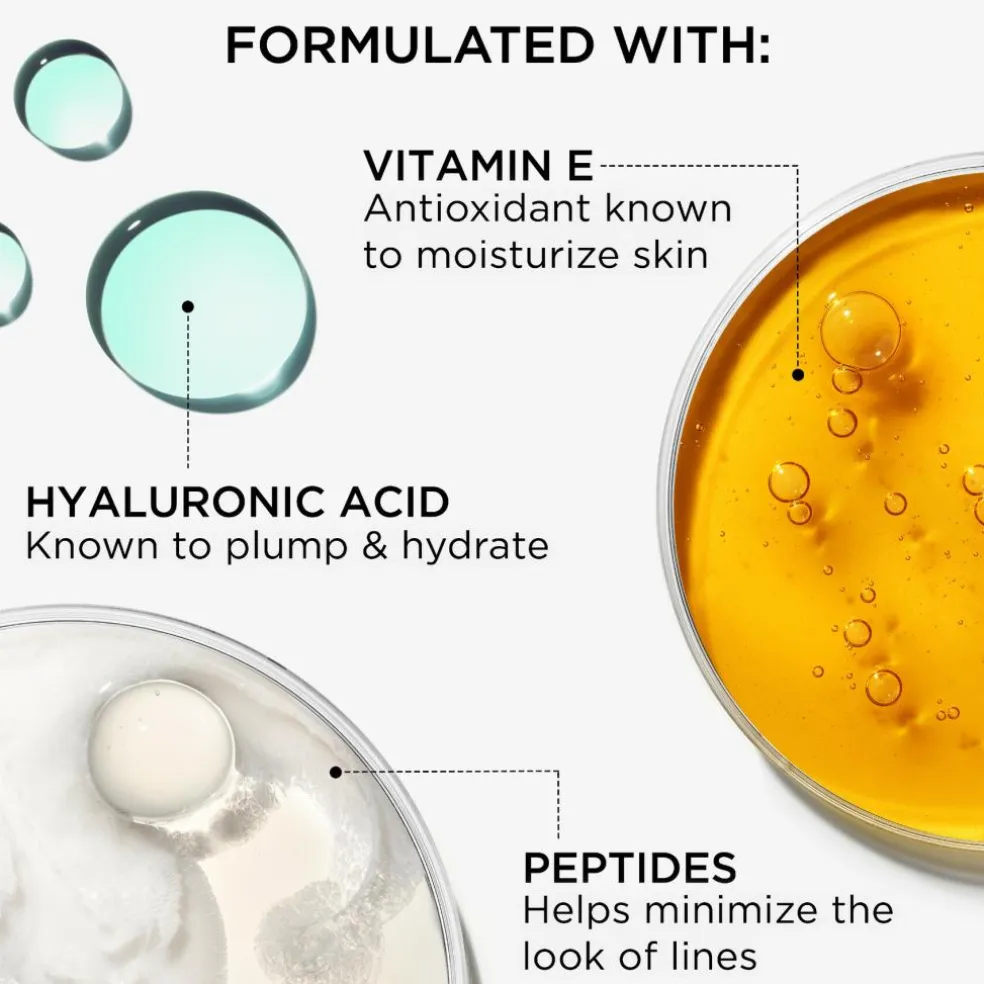
Do It All Serum Color Balm

Med 24 timers hydrering møder vores 92 % faste serum hudplejebase med hyaluronsyre, peptider og E-vitamin blush- og bronzerpigmenter for en naturlig, glødende hudfinish.
Din hudplejende blush smelter ubesværet ind i huden, samtidig med at den udglatter og fyldiggør for at tilføje dimension og løft til dit ansigt i 5 solkyssede nuancer, der passer til enhver hudtone.
Hudvenlig formel:
-Velegnet til sensitiv hud
-Dermatologisk testet
-Ikke-komedogen
-Velegnet til alle hudtyper
Anvendelse
Sådan påføres den som blush:
Brug en Heavenly Luxe-pensel, og dup let penslen ned i krukken.
Dup eller blend forsigtigt på eller lidt over æblet af kinderne, blend opad og udad.
Sådan påføres den som bronzer:
Brug en Heavenly Luxe-pensel, og dup let penslen ned i krukken.
Dup og blend let omkring hårgrænsen, panden, næsen og kindbenenes hulninger.
For en all-over farve:
Brug en Heavenly Luxe-pensel, og dup let penslen ned i krukken.
Dup og blend let på de højeste punkter i ansigtet: kinder, pande, næse og øjenlåg.
IT Tip:
For at trække opmærksomheden tilbage til ansigtet og give et ekstra løft:
Start på (eller lidt over) æblet af kinderne.
Skab et C og et baglæns C på den anden side.
Afslut med at tilføje et lille plus tegn (+) på næseryggen og næsetippen.
Du kan endda lægge lidt på dine øjenlåg, og du er klar til at gløde!
Brug en Heavenly Luxe-pensel, og dup let penslen ned i krukken.
Dup eller blend forsigtigt på eller lidt over æblet af kinderne, blend opad og udad.
Sådan påføres den som bronzer:
Brug en Heavenly Luxe-pensel, og dup let penslen ned i krukken.
Dup og blend let omkring hårgrænsen, panden, næsen og kindbenenes hulninger.
For en all-over farve:
Brug en Heavenly Luxe-pensel, og dup let penslen ned i krukken.
Dup og blend let på de højeste punkter i ansigtet: kinder, pande, næse og øjenlåg.
| Indhold | 1 stk |
| Mærke | |
| Kategori | |
| Se alt | |
| Varenummer | 1021354 |
| EAN | 3605973063921 |

Reviews
There are no reviews yet.